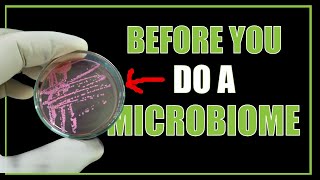

I empower YOU to overcome fatigue and reclaim vibrant energy through personalized, evidence-based natural medicine and holistic coaching. My tailored plans, rooted in 20 years of clinical experience, address hormonal imbalances, weight gain, and burnout without pharmaceuticals.
My MISSION: Help Sick, Tired YOU to be HEALTHY and ENERGETIC without needing constant costly medical support.
This channel will provide weekly wellness tips, research reviews, and the latest functional medicine knowledge to give you the support you need to achieve your ultimate wellness.
Shannon Burford has been helping patients for over 20 years with functional medicine, naturopathy and everything holistic healthcare from Australia. This has allowed him to share his wisdom and support to thousands globally.
If you have any questions, comment on any video and we’ll reply.
#alwaystired #adrenalfatigue #chronicfatigue #naturopathy #nutrition #herbalmedicine #functionalmedicine #holistichealth #naturopath
Shared 1 month ago
90 views
Shared 5 months ago
27 views
Shared 6 months ago
35 views
Shared 6 months ago
116 views
Shared 7 months ago
228 views
Cura Medicine and Brad Parkinson Naturopath BHSc.
Shared 7 months ago
877 views
Shared 7 months ago
12 views
Shared 7 months ago
20 views
Shared 8 months ago
218 views
Shared 9 months ago
135 views
Shared 10 months ago
49 views
Shared 10 months ago
29 views
Shared 11 months ago
171 views
Shared 11 months ago
112 views
Shared 1 year ago
35 views
Shared 1 year ago
54 views
Shared 1 year ago
18 views
Shared 1 year ago
72 views
Shared 2 years ago
18 views
Shared 2 years ago
53 views